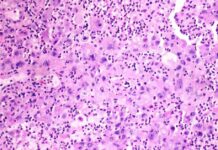
David Epstein launches new cancer startup after Novartis and Seagen career news-28102024-163033

Foot health is an essential aspect of overall well-being that is often overlooked. Our feet are a complex system of bones, joints, muscles, tendons, and ligaments that support our body weight and allow us to move. Just like any other part of our body, our feet require care to remain healthy and prevent potential problems in the future.
There are various common foot problems that one may encounter, such as athlete’s foot, bunions, corns, calluses, hammer toe, ingrown toenails, plantar fasciitis, and diabetic foot ulcers. These issues can cause discomfort, pain, and even signal underlying health problems like arthritis, diabetes, or nerve damage. It is crucial to pay attention to any changes in the skin or nails, pain, swelling, redness, tingling, burning, numbness, or difficulty walking, as early detection is key to preventing further complications.
For individuals with diabetes, proper foot care is especially important due to the risk of decreased blood flow and nerve damage in the feet. Simple steps can be taken to ensure happy and healthy feet, including washing the feet daily, checking for any abnormalities, trimming toenails correctly, wearing comfortable shoes, and staying active through stretches and exercises. It is also recommended to elevate the feet when sitting for extended periods to improve blood flow and take breaks to move the body.
By following these steps and listening to your feet, you can maintain good foot health and prevent potential issues from arising. Remember, your feet are your foundation, so treat them well, and they will take care of you in return.